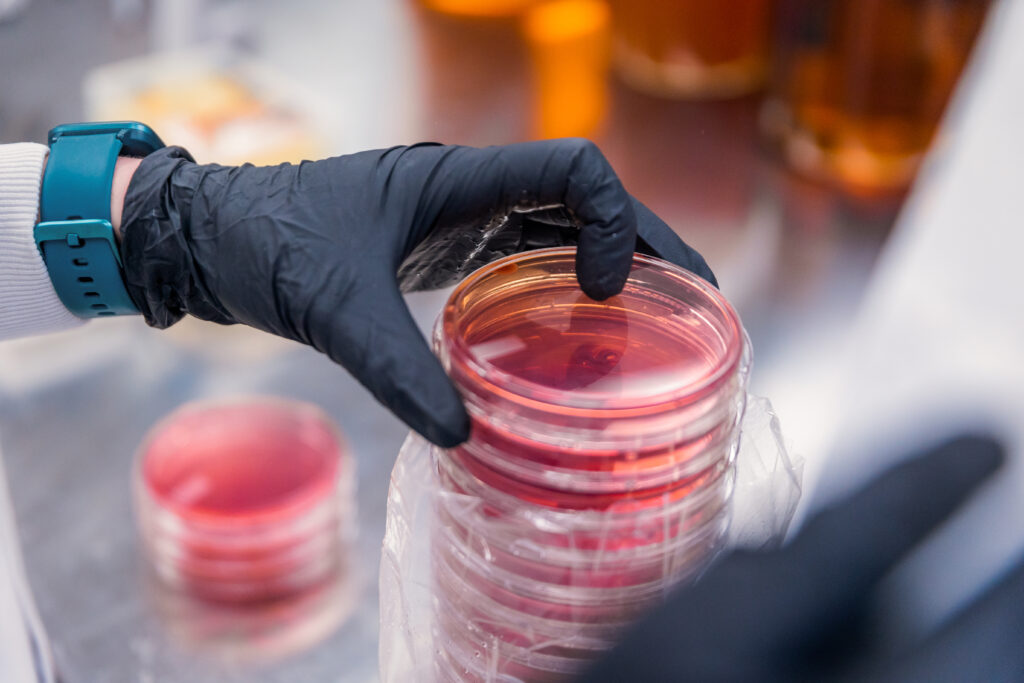
nutri-biome-lab (1)
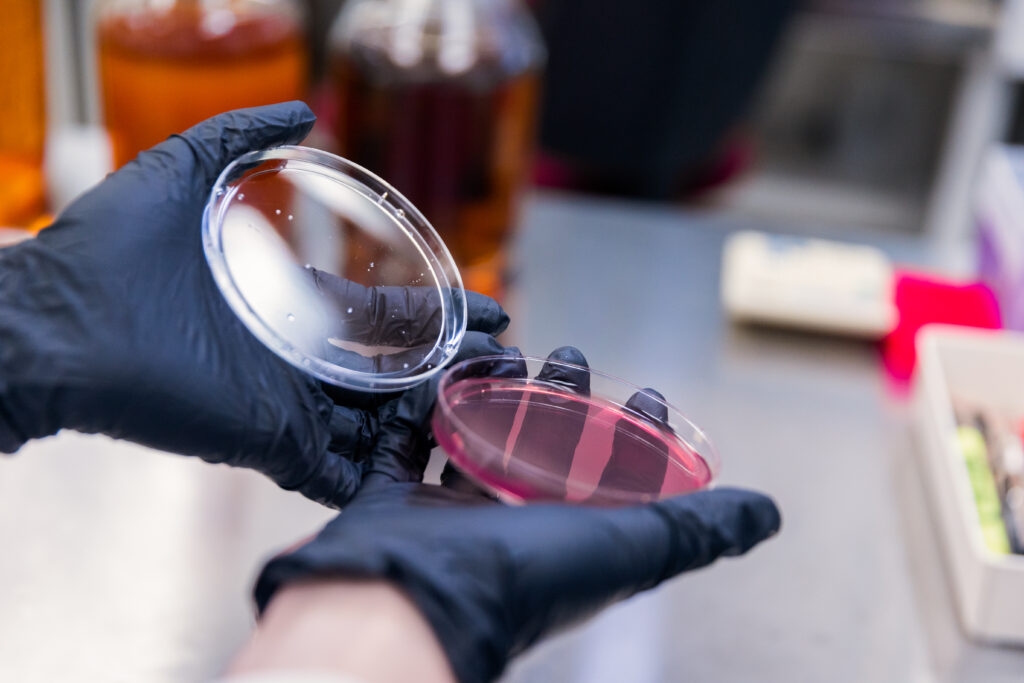
nutri-biome-lab (9)

Science → Knowledge
Our team of experts has years of experience in various fields of science, including microbiology, genetics, molecular biology, genomics, transcriptomics, metabolomics, and nutrition. This diverse range of expertise allows us to take the latest scientific research and turn it into actionable health insights and practical health suggestions. In other words, we use our knowledge of science to help you improve your health and well-being.